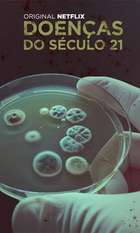
Afflicted

Home › Web Series › NASA's Unexplained Files : Season 6

Show
Disclaimer: All content and media belong to original content streaming platforms/owners like Netflix, Disney+ Hotstar, Amazon Prime Videos, JioCinema, SonyLIV etc. 91mobiles entertainment does not claim any rights to the content and only aggregate the content along with the service providers links.